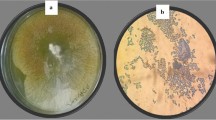

Abstract
We have established a reproducible strategy to purify hydrophilic phytotoxins present in the aqueous filtrate of Mycosphaerella fijiensis Morelet. The lyophilized culture filtrate is initially treated with activated charcoal, then successively purified using vacuum liquid chromatography and semipreparative high performance liquid chromatography. Phytotoxic activity was tested using a leaf-spot assay on healthy banana leaves.
Similar content being viewed by others
Avoid common mistakes on your manuscript.
Phytotoxins are defined as low molecular weight, secondary metabolites produced by phytopathogens that may cause necrosis, chlorosis, wilting, or a combination of these symptoms in susceptible plant hosts (Huang 2001; Knoche and Duvick 1987; Prell and Day 2000). These metabolites have been classified according to their role in the infectious process as host selective toxins (HSTs) or non-host selective toxins (non-HSTs) (Ballio and Graniti 1991; Knogge 1996; Walton 1996; Wolpert et al. 2002).
HSTs are considered as primary determinants of pathogenicity because their production is required for the pathogen to colonize the plant. Furthermore, these metabolites can induce the symptoms of the disease even in absence of the pathogen and are toxic only to hosts of the pathogen that produces them (Markham and Hille 2001; Walton 1996; Wolpert et al. 2002). On the other hand, non-HSTs are not essential for the infection, but they contribute to the virulence of the pathogen and are thus recognized as secondary determinants of pathogenicity; these metabolites can affect a wider or different range of hosts, causing a variety of symptoms (Ballio and Graniti 1991; Knogge 1996; Mitchell 1984). Phytotoxins can exert their effects by inhibiting specific enzymes or by interfering with membrane functions or defense responses (Strange 2007). Potential applications of phytotoxins include their use as probes for studying the molecular basis of disease resistance and susceptibility in plants, as tools for the in vitro screening and breeding of disease resistant plants, and as natural alternatives to herbicides in weed control (Berestetskiy 2008; Harelimana et al. 1997; Okole and Schulz 1997; Strobel et al. 1991).
The hemibiotrophic fungal pathogen Mycosphaerella fijiensis is recognized as the causal agent of black sigatoka, the most destructive and devastating disease of bananas and plantains in nearly all banana-growing regions of the world (Carlier et al. 2000). The disease significantly decreases banana production by premature ripening of the fruits and lower photosynthetic activity from a reduction in leaf area (Sanchez and Cárdenas 2002). The symptoms of the disease include elongated, necrotic lesions surrounded by chlorotic zones, suggesting the involvement of phytotoxins (Upadhyay et al. 1990).
Even though a number of lipophilic phytotoxins have been reported from organic extracts of M. fijiensis (Hoss et al. 2000; Stierle et al. 1991; Upadhyay et al. 1990), to date no hydrophilic phytotoxins have been identified from this pathogen. Recently, phytotoxic activity was detected, using the leaf-spot assay on banana leaves, in both the organic extract and the aqueous residual phase obtained after the ethylacetate extraction of culture filtrates of M. fijiensis grown in V-8 juice medium. The differing solubilities indicated the production of two groups of phytotoxic metabolites by M. fijiensis, one lipophilic and the other of hydrophilic nature (Puch-Ceh 2001). These results did not agree with those reported by Stierle et al. (1991), who found no evidence of hydrophilic phytotoxins produced by M. fijiensis in M-1-D medium. Furthermore, while Stierle et al. (1991) reported that the phytopathogen produces a high yield of lipophilic fraction when cultured in M-1-D medium; culturing of M. fijiensis in V-8 juice medium results in a lipophilic fraction that is low in yield (21.3 mg/l) and moderately active (Puch-Ceh 2001). As part of our interest in the phytotoxic metabolites produced by M. fijiensis and the study of their role in the infectious process, we describe here the production of hydrophilic phytotoxins by M. fijiensis.
Technical-grade solvents, distilled in the laboratory, together with analytical (J.T. Baker, Xalostoc, Edo. de México, México) and high performance liquid chromatography (HPLC) grade (J.T. Baker) solvents were used in the various extraction and purification procedures. Solvents were evaporated under reduced pressure using a rotary evaporator (Büchi, Postfach, Flawil, Switzerland, model 111) equipped with a water bath (Büchi, model 461), which was kept at 40°C. Aqueous fractions were lyophilized using a LABCONCO freeze dryer model 7753020 (Kansas City, USA). Vacuum liquid chromatography (VLC) and column chromatography purifications were carried out using TLC-grade E.M. Merck (Darmstadt, Germany) silica gel 60GF and Aldrich (Milwaukee, WI, USA) silica gel (70–230 mesh), respectively.
The different fractions were monitored by analytical HPLC using a Waters 600 series system (Milford, MA, USA), equipped with a Waters 2487 UV/Vis detector and a Waters 600E controller loaded with the program Millenium. Separations were carried out using a Waters C18 Spherisorb analytical column (5 μm ODS2; 4.6 mm inner diameter, 250 mm long) and a 10:90 mixture of CH3CN:buffer (K2HPO4, 25 mM, pH 2.5 adjusted with perchloric acid) as the mobile phase; with a flow rate of 0.3 ml/min and the detector set at both 240 and 260 nm. Phytotoxic fractions were purified by semipreparative HPLC using a Hypersyl C18 (Alltech, Deerfield, IL, USA) preparative column (120 8U; 10 mm inner diameter, 250 mm long), and the same 10:90 mixture of CH3CN:buffer (K2HPO4, 25 mM, pH 2.5 adjusted with perchloric acid) as the mobile phase, with a flow rate of 0.6 ml/min, monitoring at 240 and 260 nm.
The strain of M. fijiensis (C-1233) was kindly donated by Dr. Jean Carlier (CIRAD, France). The banana plant material (corms and buds of Musa acuminata cv. Grande Naine) used for establishing in vitro cultures was provided by Alberto Mayo (UJAT, Villermosa, Tabasco, México).
Cultures of the fungus were grown in 500 ml flasks containing 200 ml of V-8 juice (Herdez, México, DF, México) medium with 2 g CaCO3/l. The pH of the medium was adjusted to 5.5 with 1 N HCl prior to sterilization. Each flask was inoculated with 1 ml of an aqueous suspension of fresh mycelium and conidia, then incubated in an orbital shaker at 150 rpm (New Brunswick Scientific, Orbital Shaker Model G25), at 26 ± 2°C, for 30 days, under photoperiod (12 h light/12 h dark) conditions. After the incubation period, the culture broth was separated from the mycelial mat by filtration through two layers of gauze and paper towels, and the volume of the filtrate was concentrated in vacuo to 1/10 of its original volume. The resulting concentrated filtrate was then lyophilized.
The phytotoxic activity of the filtrate and the different purified fractions was evaluated using a leaf-spot assay on healthy leaves of banana plants (M. acuminata cv Grande naine) growing in pots under greenhouse conditions. The first or second youngest leaf of a 4-month-old banana plant was excised, then disinfected for 60 s using a 5% solution of commercial sodium hypochlorite (Clorox, Tlalnepantla, Edo. de México, México). The leaves were rinsed with sterile distilled water, dried between two paper towels and placed in a plastic container, previously disinfected with 70% ethanol, lined with five wet paper towels.
A 20 μl drop of the filtrate or different fractions (2 or 3% solution) was placed on a wound made with a scalpel in the adaxial face of the leaf. Two leaves were used for each treatment, and the container was kept at room temperature under natural light conditions. The phytotoxic effects (i.e., total damaged area, including necrosis and chlorosis) were registered at 72 h after treatment; the lesion area was calculated using a leaf area measurer (Li-3100; Li-Cor, Lincoln; Nebraska, USA). Both sterile uninoculated medium and water were used as controls. All evaluations were done in duplicate.
The lyophilized crude filtrate (A, 10 g) was resuspended in water (1:50 lyophilized filtrate to water) and treated with activated charcoal (1:5 lyophilized filtrate to activated charcoal). The resulting suspension was left to stir slowly overnight at 40°C, and then filtered. The clarified filtrate was concentrated to 1/10 of its original volume and then lyophilized to produce a pigment-free fraction B (7.1 g, 71%). Extraction (methanol) of the residual activated charcoal yielded 0.2 g (2%) of fraction C.
A portion of pigment-free fraction B (1 g) was purified by VLC using a stepwise gradient elution with dichloromethane/methanol/water (14:7:1 to 10:10:1) mixtures, which yielded 12 fractions (D1 to D12). Leaf-spot assay evaluation of all fractions at 3% indicated that phytotoxic activity was located in fractions D5 (167.8 mg) and D6 (138.6 mg).
The phytotoxic fractions D5 and D6 were combined to produce fraction E. Semipreparative HPLC purification of fraction E (250 mg) produced fractions F3 (peak at t R 18.8 min) and F4 (peak at t R 28.9 min), which were lyophilized and then desalted by column chromatography (isocratic elution, dichloromethane/methanol/water 14:7:0.5), to yield the corresponding fractions G (2.2 mg) and H (1.5 mg), each a major component in HPLC. The phytotoxic activity of all fractions was evaluated at 2% using the leaf-spot assay.
It is important to mention that initial attempts to purify the hydrophilic phytotoxins from the lyophilized crude culture filtrate of M. fijiensis using a number of different chromatographic techniques and fractionation procedures, e.g., solid-phase extraction [Amberlite XAD-2 (Supelco, Bellefonte, PA, USA) and Diaion HP-20 (Nippon Rensui, Kanagawa, Japan)], reverse-phase (C18) (Sigma-Aldrich, St. Louis, MO, USA) chromatography, and gel filtration chromatography (Sephadex LH-20, Uppsala, Sweden), were hampered by the pigments in the lyophilized crude filtrate. However, treatment of the lyophilized crude filtrate (A) with activated charcoal produced a pigment-free fraction (B), which caused more phytotoxic damage than did the original lyophilized crude filtrate (A) (Fig. 1a). This finding suggests that the hydrophilic phytotoxins produced by M. fijiensis and present in the pigment-free fraction B (Fig. 1b), are different than those previously identified and reported as melanin shunt pathway metabolites (Stierle et al. 1991).
Phytotoxic damage on banana leaf caused by the crude filtrate of Mycosphaerella fijiensis (A) and the pigment-free fraction (B) tested at 3% (w:v). a The pigment-free fraction (B) caused more damage than did the original crude filtrate (A). Fraction C, from the methanol extraction of the residual activated charcoal, did not cause significant damage when tested at 3% on banana leaves. Both sterile uninoculated medium and water (H2O) were used as controls. Damaged tissue around the wound (necrosis and chlorosis) was quantified using a foliar area measurer (Li-COR, Lincoln; Nebraska, USA Li-3100). b Physical appearance (dark powder) of the lyophilized culture filtrate of M. fijiensis (A) before treatment with activated charcoal; lyophilized pigment-free fraction (B); and methanol extract of the residual activated charcoal (C)
Attempts to fractionate the pigment-free fraction B, using solid-phase extraction, reverse-phase, and gel filtration chromatography, were unsuccessful. However, VLC purification of fraction B resulted in the isolation of two semipurified fractions (D5 and D6) with phytotoxic activity when tested at 3% (w:v) (Fig. 2). The HPLC analysis of the two phytotoxic fractions showed the presence of two common components at t R 18.8 min and t R 28.9 min (Fig. 3a, b).
Phytotoxic damage of banana leaf caused by fractions D5 and D6, obtained by vacuum liquid chromatography purification of fraction B from Mycosphaerella fijiensis. Fractions D5 and D6 were phytotoxic when tested at 3% (w/v) in the leaf-spot assay. Fraction E, resulting from the combination of fractions D5 and D6, also was phytotoxic at 3% (w/v). Sterile uninoculated medium and water (H 2 O) were used as controls. Damaged tissue around the wound (necrosis and chlorosis) was quantified using a foliar area measurer (Li-COR, Lincoln; Nebraska, USA Li-3100)
Chromatographic profiles (HPLC) of phytotoxic fractions obtained by vacuum liquid chromatography of culture filtrate of Mycosphaerella fijiensis. a Fraction D5. b Fraction D6. In the HPLC chromatographic profile of both phytotoxic fractions there were two similar components at t R 18.8 min and t R 28.9 min. The fractions were analyzed by analytical HPLC on a Waters C18 Spherisorb analytical column (5 μm ODS2; 4.6 mm inner diameter, 250 mm long), with a 10:90 mixture of CH3CN:buffer (K2HPO4, 25 mM, pH 2.5 adjusted with perchloric acid) as the mobile phase, with a flow rate of 0.3 ml/min, and the detector set at 240 and 260 nm
Purification of the combined phytotoxic fractions D5 and D6 (to produce phytotoxic fraction E, Fig. 2) by semipreparative HPLC yielded two fractions, F3 (t R 18.8 min) and F4 (t R 28.9 min) which, after a desalting procedure by column chromatography, yielded fractions G and H, each showing a major component on HPLC (Fig. 4b, c), and both causing more phytotoxic damage than did the original fraction E, when tested at 2% (w:v) (Fig. 4a).
Phytotoxic damage of banana leaf caused by purified fractions from culture filtrate of Mycosphaerella fijiensis tested at 2% (w/v). a Fractions G and H caused more damage than did the original sample (E). Sterile uninoculated medium and water (H 2 O) were used as controls. b Chromatographic profile (HPLC) of fraction G. c Chromatographic profile (HPLC) of fraction H
This report is the first on hydrophilic phytotoxins being produced by M. fijiensis and to present a simple strategy to purify them. Presently, we are isolating more of fractions G and H. The identification of the chemical structure of the purified metabolites will soon be published.
References
Ballio A, Graniti A (1991) Phytotoxins and their involvement in plant diseases. Experientia 47:751–826
Berestetskiy AO (2008) A review of fungal phytotoxins: from basic studies to practical use. Appl Biochem Microbiol 44:453–465
Carlier J, Fouré E, Gauhl F, Jones DR, Lepoivre P, Mourichon X, Pasberg-Gauhl C, Romero RA (2000) Fungal diseases of foliage. In: Jones DR (ed) Diseases of banana, abacá and ensete. CABI Publishing, Wallingford, pp 37–141
Harelimana G, Lepoivre P, Jijakli H, Mourichon X (1997) Use of Mycosphaerella fijiensis toxins for the selection of banana cultivars resistant to black leaf streak. Euphytica 96:125–128
Hoss R, Helbig J, Bochow H (2000) Function of host and fungal metabolites in resistance response of banana and plantain in the black sigatoka disease pathosystem (Musa spp.–Mycosphaerella fijiensis). J Phytopathol 148:387–394
Huang JS (2001) Plant pathogenesis and resistance: biochemistry and physiology of plant–microbe interactions. Kluwer Academic Publishers, Dordrecht, pp 292–383
Knoche HW, Duvick JP (1987) The role of fungal toxins in plant disease. In: Pegg GF, Ayres PG (eds) Fungal infection of plants. Symposium of the British Mycologial Society. Cambridge University Press, Cambridge, pp 158–192
Knogge W (1996) Fungal infection of plants. Plant Cell 8:1711–1722
Markham JE, Hille J (2001) Host-selective toxins as agents of cell death in plant–fungus interactions. Mol Plant Pathol 2:229–239
Mitchell RE (1984) The relevance of non-host-specific toxins in the expression of virulence by pathogens. Annu Rev Phytopathol 22:215–245
Okole BN, Schulz FA (1997) Selection of Mycosphaerella fijiensis-resistant cell lines from micro-cross sections of banana and plantain. Plant Cell Rep 16:339–343
Prell HH, Day PR (2000) Plant–fungal pathogen interaction: a classical and molecular view. Springer, New York, pp 57–64
Puch-Ceh MA (2001) Evaluación de la actividad fitotóxica en cultivos de Mycosphaerella fijiensis Morelet mediante el uso de diferentes técnicas de bioensayo (in Spanish). Masters thesis, Centro de Investigación Científica de Yucatán, Mérida, Yucatán, México
Sanchez M, Cárdenas W (2002) Producción de anticuerpos policlonales contra el hongo causante de la sigatoka negra, Mycosphaerella fijiensis (in Spanish). Revista Tecnológica 15:55–61
Stierle AA, Upadhyay R, Hershenhorn J, Strobel GA, Molina G (1991) The phytotoxins of Mycosphaerella fijiensis, the causative agent of Black Sigatoka disease of bananas and plantains. Experientia 47:853–859
Strange RN (2007) Phytotoxins produced by microbial plant pathogens. Nat Prod Rep 24:127–144
Strobel G, Kenfield D, Bunkers G, Sugawara F, Clardy J (1991) Phytotoxins as potential herbicides. Experientia 47:819–826
Upadhyay RK, Strobel GA, Coval SJ, Clardy J (1990) Fijiensin, the first phytotoxin from Mycosphaerella fijiiensis, the causative agent of Black Sigatoka disease. Experientia 46:982–984
Walton JD (1996) Host-selective toxins: agents of compatibility. Plant Cell 8:1723–1733
Wolpert TJ, Dunkle LD, Ciuffetti LM (2002) Host-selective toxins and avirulence determinants: what’s in a name? Annu Rev Phytopathol 40:251–285
Acknowledgments
This investigation was supported by Project 2004-168 SAGARPA-CONACyT. The authors thank Cecilia Mónica Rodríguez-García and Leticia Peraza-Echeverría (UBT-CICY) for providing the certified strain of M. fijiensis (C-1233), Alberto Mayo-Mosqueda for establishing the in vitro cultures of banana plants, and Silvia Beatriz Andrade-Canto for technical assistance.
Author information
Authors and Affiliations
Corresponding author
Electronic supplementary material
Below is the link to the electronic supplementary material.
Rights and permissions
About this article
Cite this article
Cruz-Cruz, C.A., García-Sosa, K., Escalante-Erosa, F. et al. Production of hydrophilic phytotoxins by Mycosphaerella fijiensis . J Gen Plant Pathol 75, 191–195 (2009). https://doi.org/10.1007/s10327-009-0165-1
Received:
Accepted:
Published:
Issue Date:
DOI: https://doi.org/10.1007/s10327-009-0165-1